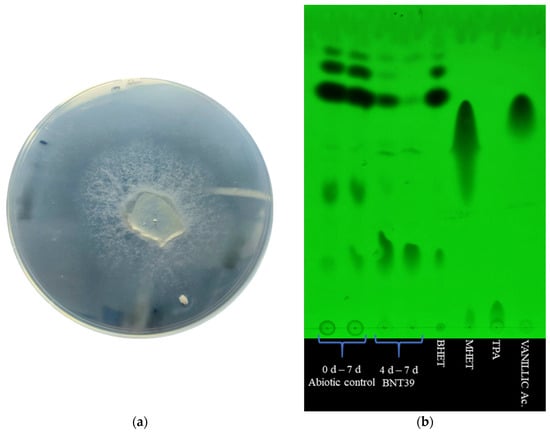

Abstract
The accumulation of polyethylene terephthalate (PET) in the environment demands efficient microbial strategies for its degradation. This study evaluates the biodegradation potential of Schizophyllum commune BNT39 toward bis(2-hydroxyethyl) terephthalate (BHET), a major PET intermediate, and PET itself. Clear halos on BHET-agar plates indicated extracellular hydrolytic activity. In liquid culture, thin-layer chromatography (TLC) and high-performance liquid chromatography (HPLC) analyses revealed a three-phase degradation profile characterized by rapid BHET hydrolysis, transient dimer accumulation, and subsequent conversion to terephthalic acid (TPA). BHET was reduced by approximately 96% within seven days, while TPA accumulation reached 0.8 mg/mL after 30 days of incubation. Although PET degradation was limited, TPA was consistently detected as the principal product, with no BHET or MHET intermediates. To explore strategies for enhancing enzymatic activity, apple-derived cutin, PET, BHET, and polycaprolactone (PCL) were tested as inducers. Cutin markedly stimulated extracellular enzyme production, suggesting activation of cutinase-like enzymes. Overall, S. commune BNT39 demonstrates the ability to transform PET-related substrates, with cutin emerging as a promising natural stimulant to enhance enzymatic depolymerization. Future studies should focus on enzyme purification, activity profiling, and reaction optimization near PET’s glass transition temperature, where the polymer becomes more accessible for enzymatic attack.
1. Introduction
The accelerating production and use of petroleum-derived plastics has created a persistent waste burden, with ~400 million metric tons produced in 2022 and ~79% mismanaged or landfilled; PET is among the most widely used polymers (~24 million tons in 2022), and end-of-life management still often relies on incineration or landfilling [1]. PET’s semi-crystalline durability underlies its recalcitrance, highlighting the need for sustainable alternatives to conventional physical and chemical recycling routes [2]. In parallel, PET contributes to micro- and nanoplastic pollution across soils and aquatic systems, raising ecosystem and human health concerns [3]. Conventional chemical recycling strategies (e.g., glycolysis, microwave-assisted depolymerization, catalytic hydrolysis) can recover monomers but frequently demand high energy, employ toxic catalysts, or generate undesirable byproducts [2,4]. As a greener complement, biological depolymerization uses microbial enzymes to hydrolyze polyester ester bonds, yielding soluble monomers and oligomers that can be assimilated and mineralized [5]. Over the past two decades, specialized hydrolases—collectively termed PETases, largely within the cutinase–lipase–carboxylesterase family (EC 3.1.1.-)—have emerged as promising biocatalysts for PET, producing terephthalic acid (TPA) and ethylene glycol (EG) with potential advantages in environmental compatibility and process specificity [3,6,7].
In enzymatic PET depolymerization, bis (2-hydroxyethyl) terephthalate (BHET) and mono (2-hydroxyethyl) terephthalate (MHET) are key intermediates: PETases generate MHET, BHET, and EG, while MHETases hydrolyze MHET to TPA and EG [2]. Because BHET and MHET can accumulate and impede overall mineralization, enzymes that efficiently transform BHET-BHETases are strategically important to drive reactions toward full depolymerization [8]. Recent work has identified conserved BHETases in Streptomyces (LipA variants), which degrade BHET and roughen amorphous PET films under mild conditions, highlighting the ecological prevalence and catalytic relevance of BHET-targeting esterases [1]. The bacterium Ideonella sakaiensis produces a PETase-MHETase enzyme pair that efficiently converts PET into TPA and EG under mild conditions (~30–40 °C), and engineered variants now reach up to 90% depolymerization of amorphous PET in less than 10 h [3,7]. However, while PETase and MHETase from bacteria have been extensively characterized, fungal BHETases remain largely unexplored, representing a significant gap in current knowledge [2]. BHET has been recognized as a pivotal intermediate in PET depolymerization, and sequential enzymatic strategies have been proposed to enhance its conversion into monomers such as TPA, underscoring its importance in PET recycling pathways [9].
Source selection is also critical for discovering robust polyester hydrolases. Plant cuticles are rich in the lipid polyester cutin, a natural substrate for cutinases; phytopathogenic fungi frequently encode multiple cutinase genes, and cuticle-based inducers (e.g., cacao or apple cuticles) can upregulate fungal cutinase expression [3,10]. This ecological association provides a rationale for isolating microorganisms from cutin-rich plant materials to access diverse cutinases with potential cross-reactivity toward synthetic polyesters such as PET [3,10].
Within this context, fungi offer distinct advantages over bacteria as sources of PET-active enzymes. Filamentous fungi secrete abundant exoenzymes and hydrophobins, enabling adhesion to hydrophobic polymers, hyphal penetration of materials, and non-specific extracellular depolymerization of recalcitrant substrates [5]. Fungal hydrolases (lipases, carboxylesterases, cutinases) and oxidoreductases have been repeatedly implicated in PET degradation, supporting their promise for biotechnological application [5]. In comparative terms, reviews note that fungi often express biodegradation enzymes more effectively than bacteria, further motivating fungal bioprospecting for PET hydrolases [8]. Moreover, fungi can secrete organic acids and surfactants that enhance PET surface hydrophilicity, potentially alleviating the crystallinity barrier that constrains enzymatic access [5]. Among fungi, Fusarium solani produces a well-characterized cutinase (FsC) that hydrolyzes PET films and fibers, achieving up to 90% conversion when reaction parameters are optimized [11]. Rhodococcus sp. synthesizes a PBAT/PET-hydrolyzing cutinase (Rcut) with a typical α/β-hydrolase fold and catalytic triad (Ser–His–Asp), active at 40 °C and capable of degrading PET and polycaprolactone [12]. The basidiomycete Moniliophthora roreri expresses multiple cutinases (MRCUT1–3), one of which, MRCUT1, caused 31% weight loss of PET films within 21 days, accompanied by marked surface erosion confirmed by SEM analysis [3]. In submerged cultures, Penicillium simplicissimum increased lipase activity nearly two-fold when induced by BHET and achieved ~3.1% mass loss of post-consumer PET fragments after 28 days; its extracellular enzymes released MHET as the major product during BHET hydrolysis, pointing to intermediate-level bottlenecks that targeted BHETases could alleviate [13]. Additional reports show fungal consortia (e.g., Aspergillus niger + Trichoderma harzianum) producing detectable PET weight loss and FTIR-evident scission of ester bonds under mild conditions [2]. These findings support the ecological and technological relevance of fungal PET degraders.
While less explored, Schizophyllum commune has emerged as a versatile white-rot basidiomycete producing extracellular hydrolases and laccases under diverse conditions, and recent studies demonstrate its ability to depolymerize polyester-like substrates and lignocellulosic polymers through secreted oxidative and hydrolytic enzymes [14]. Schizophyllum commune remains comparatively underexplored regarding polyester depolymerization, but its ecological lifestyle and extracellular enzyme arsenal make it a plausible source of secreted hydrolases responsive to cutin-like inducers.
Finally, recent advances in metabolic engineering of yeasts and bacteria illustrate the potential to not only degrade PET but also to valorize its monomers into high-value products, such as vanillin—a microbial metabolite synthesized from TPA—or specialty chemicals, broadening the scope of biotechnological applications [3,15].
Building on these insights, the present study aims to evaluate a novel fungal isolate, Schizophyllum commune BNT39, for its ability to degrade BHET and PET, characterize its enzymatic pattern, and explore natural inducers such as apple cutin for enhanced cutinase activity. Preliminary findings indicate that the fungal isolate was capable of degrading both BHET and PET to varying extents, and that cutin added to the culture medium improved cutinase activity, underscoring its potential for further development in polyester biodegradation.
2. Materials and Methods
2.1. Fungal Isolation and Identification
2.1.1. Fungal Isolation and Culture Conditions
Plant material visibly overgrown with fungi was collected from “Las Yungas” rainforest (Tucumán, Argentina). One gram of the sample sectioned into small pieces was placed in an Erlenmeyer flask containing 15 mL of wash solution (0.5% yeast extract, 0.1% glucose, and 0.2% Tween 80). Then, the flask was incubated at 200 rpm, 25 °C for 30 min to separate the fungal cells from the plant material [16]. The obtained suspension was serially diluted, and 100 μL was spread on APG medium plates (10 g/L glucose dissolved in 1 L of potato extract, and 15 g/L agar). Plates were incubated at 30 °C and examined daily for five days. Fungal colonies were selected based on macroscopic differences and subsequently characterized. Finally, one isolated fungus was selected for further studies. This strain, named BNT39, was deposited in the Genetic Resource Collection of PROIMI-CONICET (Tucumán, Argentina).
2.1.2. Molecular Identification
The fungus under study was cultivated in yeast-peptone-glucose (YPD) medium, consisting of 1% (w/v) yeast extract and 2% (w/v) bacteriological peptone, and 2% glucose (w/v); all purchased from Britania, Ciudad Autónoma de Buenos Aires, Argentina. The fungus was incubated at 30 °C for 24 h on an orbital shaker (200 rpm). Mycelia were then collected by centrifugation at 10,000 rpm (10 min, 4 °C) and finally washed twice with sterile distilled water. Total DNA was extracted using the QIAamp DNA kit (QIAGEN, Ciudad Autónoma de Buenos Aires, Argentina), and its quality was verified by agarose gel electrophoresis (0.8%). DNA concentration was determined using a Nanodrop spectrophotometer (Thermo Fisher Scientific, Waltham, MA, USA).
The LSU region was amplified and sequenced in this study. This region spanned the ITS1, 5.8S, ITS2, and D1/D2 domain of the 28S rDNA. The sequence was amplified by using universal primers ITS1 (TCC GTA GGT GAA CCT GCG G) and NL4 (GGT CCG TGT TTC AAG ACG G) [17]. Nucleotide sequencing of the genes was performed by Macrogen Inc. (Seoul, Republic of Korea). Sequences were analyzed and trimmed when necessary, using BioEdit Sequence Alignment Editor software (7.7.1 version) [18]. After consensus sequences generation, strain identification was performed by comparison with sequences from type strains available in the GenBank database using the provided BLAST tool (https://blast.ncbi.nlm.nih.gov/Blast.cgi, accessed on 5 November 2025) from the National Center for Biotechnology Information (NCBI). Arbitrarily, a ≥98% identity and ≥99% coverage criterion was employed to identify the strain at the species level. The DNA sequence generated in this study (1042 pb) was deposited in the GenBank database under the accession number PX026298.
2.2. BHET Degradation Assays
2.2.1. Hydrolysis on Solid Medium
A modified YP medium was prepared at 50% of the standard formulation, supplemented with 1.3% (w/v) agar to obtain a solid medium. The medium was further amended with 0.1% (w/v) bis(2-hydroxyethyl) terephthalate (BHET, Sigma-Aldrich, Saint Louis, MO, USA) and sterilized by autoclaving. After solidification in Petri dishes, the plates were inoculated with a small agar plug previously colonized by Schizophyllum commune BNT39 grown on solid YP medium. Cultures were incubated at 30 °C for 10 days, after which the plates were examined for the appearance of a hydrolysis halo indicative of BHET degradation [1].
2.2.2. Degradation in Liquid Medium Analyzed by Thin-Layer Chromatography (TLC)
Liquid cultures were prepared using YP 50% medium, amended with 3 mg/mL BHET, and autoclaved. For inoculation, a 7 mm diameter plug of solid YP medium recently colonized by Schizophyllum commune BNT39 was excised under sterile conditions with a sterilized puncher, finely fragmented, and used to inoculate 20 mL of liquid medium. Cultures were incubated for 7 days at 30 °C with shaking at 120 rpm in an orbital shaker-incubator. Appropriate controls consisting of YP 50% medium supplemented with BHET but without fungal inoculum (abiotic control) and YP 50% medium inoculated with the fungus but without BHET (biotic control) were prepared.
Samples (600 µL) were collected at 0, 4, and 7 days of incubation. Each sample was extracted with 300 µL of ethyl acetate (Biopack, Ciudad Autónoma de Buenos Aires, Argentina) by vortexing for 5 min to ensure partitioning of the compounds between the immiscible phases, followed by a brief centrifugation (15 s). Aliquots of 25 µL from the organic phase were spotted onto TLC Silica gel 60 RP-18 F254 plates (Merck, Darmstadt, Germany). Chromatographic separation was performed using chloroform–methanol (8:2, v/v) as the mobile phase. Standards of BHET, MHET, TPA, and vanillic acid (purchased from Sigma-Aldrich, USA) were run in parallel. After development, plates were visualized under UV light at 254 nm.
2.2.3. Quantitative Analysis by High Performance Liquid Chromatography (HPLC)
Schizophyllum commune BNT39 was cultivated in liquid YP 50% medium amended with BHET as described above and incubated under the same conditions for 30 days. Appropriate biotic and abiotic controls were also prepared.
Aliquots of 600 µL were collected at 0, 4, 7, 15, and 30 days of incubation. Each sample was mixed with an equal volume (600 µL) of chilled acetone to precipitate proteins and stored overnight at −20 °C. The samples were then centrifuged at 12,000 rpm for 5 min at 4 °C, and the supernatants were recovered. Acetone was evaporated under a fume hood, and the volume was restored to 600 µL with deionized water. Samples were subsequently mixed with an equal volume (600 µL) of the HPLC mobile phase (methanol/water 50:50, v/v, containing 0.1% acetic acid), filtered through 0.22 µm hydrophobic PTFE syringe filters (Thermo Scientific, Beijing, China), and diluted with mobile phase when necessary.
HPLC analyses were carried out using a Phenomenex (Torrance, CA, USA) Gemini C18 column (5 µm, 4.6 mm i.d. × 250 mm) maintained at 30 °C. The mobile phase consisted of methanol/water (50:50, v/v) with 0.1% acetic acid under isocratic conditions at a flow rate of 1 mL/min. Twenty microliters of each sample were injected, and detection was performed at 250 nm with spectral monitoring from 200 to 400 nm.
For compound quantification, calibration curves were constructed using authentic standards of BHET, MHET, TPA, and vanillic acid at concentrations of 0.1, 0.05, 0.025, 0.005, and 0.001 mg/mL. These curves were used for the accurate quantification of the compounds in the culture supernatants.
2.3. PET Degradation Assays
PET degradation assays were performed in liquid YP 50% medium supplemented with amorphous micronized PET film (<400 µm, Sigma-Aldrich, USA) at 3 mg/mL. The medium was sterilized by autoclaving and subsequently inoculated with a 7 mm diameter agar plug of solid YP medium previously colonized by Schizophyllum commune BNT39. Appropriate biotic and abiotic controls were also prepared.
Incubations were carried out at 30 °C with shaking at 150 rpm in an orbital shaker-incubator. Samples (600 µL) were collected after 15 and 30 days of incubation. Each sample was treated with chilled acetone to precipitate proteins and processed following the same procedure described in Section 2.2.3 for HPLC analysis. This allowed the detection and quantification of PET hydrolysis products, in order to assess the capacity of S. commune BNT39 to degrade PET under the given culture conditions.
2.4. Cutin Extraction and Characterization
Cutin was extracted by adapting the procedure described in a patent [19]. Since commercial cutin was unavailable, it was obtained in the laboratory from natural sources. Apple peels were dried in an oven at 55 °C for 24 h, ground, and sieved through a 1 mm mesh. The solids were further screened to obtain particles < 1 mm.
One gram of ground apple peels (processed in triplicate) was weighed into 50 mL centrifuge tubes, and 40 mL of 3% (w/v) NaOH solution was added. The tubes were placed in an ice bath and subjected to ultrasonication using a QSONICA Q55 probe Sonicador at 100% amplitude for 12 cycles. Each cycle consisted of 50 s sonication (On) followed by 30 s pause (Off). The ice bath was maintained throughout to avoid abrupt temperature increases.
After sonication, the samples were centrifuged at 5600 rpm for 15 min at 4 °C. The supernatants were discarded, and the pellets were resuspended in 40 mL of 40% (v/v) ethanol–water solution. The sonication step was repeated under the same conditions, followed by centrifugation, after which the supernatants were recovered. Each supernatant was transferred to a 150 mL glass flask and adjusted to pH 2.5 with 3 M HCl. The solutions were kept refrigerated for at least 4 h.
Finally, the samples were centrifuged at 8000 rpm for 15 min at 4 °C. The supernatants were discarded, and the pellets were washed with distilled water and centrifuged again under the same conditions. The resulting precipitates were stored at −20 °C until lyophilization.
A portion of the lyophilized samples was subjected to Fourier-transform infrared (FTIR) spectroscopy (Bruker, Billerica, MA, USA) to confirm the presence of cutin.
2.5. Effect of Cutin on Enzymatic Activity
To evaluate potential stimulation of cutinase activity, Schizophyllum commune BNT39 was cultivated in YP 50% medium supplemented with the following compounds (independent assays): BHET at 3 mg/mL, polycaprolactone (PCL; Sigma-Aldrich, USA) at 3 mg/mL previously dissolved in acetone, micronized PET film (<400 µm) at 3 mg/mL, and previously produced cutin at 1 mg/mL. YP 50% medium without supplementation served as the control. Cultures were incubated at 30 °C with agitation at 120 rpm in an orbital shaker-incubator. Aliquots were collected at 4, 6, 8, and 15 days of incubation and centrifuged at 12,000 rpm for 5 min. The supernatants were used for cutinase activity determinations.
Enzyme activity was measured following an adapted methodology [20] in 96-well microplates. Each reaction mixture contained 240 µL of buffer A (100 mM sodium phosphate buffer, pH 7.0, supplemented with 0.1% gum arabic and 0.4% Triton X-100), 30 µL of culture supernatant, and 30 µL of 2 mM p-nitrophenyl butyrate (pNPB; Sigma-Aldrich, USA) to initiate the reaction. Reactions were incubated at 37 °C, and enzymatic activity was monitored spectrophotometrically at 405 nm by following the release of p-nitrophenol (pNP). The amount of pNP released was quantified using a calibration curve prepared with authentic pNP (Sigma-Aldrich, USA). One unit of cutinase activity (U) was defined as the amount of enzyme required to release 1 µM of pNP per minute under the assay conditions.
2.6. Statistics
Assays were carried out in triplicate, and results are expressed as the mean ± SE. One-way analysis of variance (ANOVA) and Tukey’s post-test using MINITAB 21 Statistical Software (Minitab, State College, PA, USA) were applied for statistical analysis.
3. Results and Discussion
3.1. Degradation of BHET by Schizophyllum commune BNT39
The 1042 pb sequence corresponding to the ITS1, 5.8S, ITS2, and D1/D2 domain of LSU rDNA (GenBank accession number PX026298) was subjected to identification by comparison with the GenBank database. The sequence comparison identified the BNT39 strain as Schizophyllum commune (99,23% identity, 100% coverage). S. commune was described as a mushroom-forming basidiomycete with notable genotypic and phenotypic variability. The versatility of S. commune was also evidenced by the fact that it was reported as a saprophyte on a wide variety of plant waste, but it was also reported to be a pathogen and/or plant endophyte [21].
To evaluate the polyester-degrading potential of S. commune BNT39, initial experiments were performed using BHET as a model substrate. BHET was extensively employed as a proxy compound to investigate microbial hydrolytic activity toward PET, due to its higher solubility and simpler structure compared with the polymer [22,23]. Screening assays were conducted in both solid and liquid media to assess whether the fungal isolate could utilize or transform this substrate.
In the first instance, the hydrolytic activity of S. commune BNT39 was evaluated on a solid medium containing BHET. A clear hydrolysis halo was observed around the fungal colony from day 7 of incubation, which became more evident by day 10 (Figure 1a). This type of plate assay was commonly employed as a preliminary screening method to identify microbial isolates with the potential to degrade PET or its intermediates, as it offers a simple and visual means of detecting extracellular hydrolytic activity [1,24]. In this study, the results demonstrated that S. commune BNT39 secreted enzymes capable of hydrolyzing BHET in solid medium.
Figure 1.
Hydrolysis of BHET by Schizophyllum commune BNT39: (a) Hydrolysis halo formed on YP 50% agar plates supplemented with 1 mg/mL BHET after 10 days of incubation, indicating extracellular hydrolytic activity. (b) TLC analysis of BHET degradation in liquid YP 50% medium supplemented with 3 mg/mL BHET. The disappearance of BHET spots at 4 and 7 days demonstrated the hydrolytic activity of S. commune BNT39.
Subsequently, the hydrolytic activity of the fungus was assessed in liquid medium (YP 50%) supplemented with BHET. As shown in the TLC (Figure 1b), when compared with the abiotic control, strain BNT39 was able to moderately degrade BHET after 4 days of incubation, while by day 7, its degradation was more evident. The BHET spots decreased in intensity, almost disappearing (lane 4, Figure 1b). However, no additional products such as MHET, TPA, or vanillic acid could be detected, at least with the TLC method. In fact, this approach was implemented as a preliminary in-house technique to qualitatively monitor BHET degradation, evidenced by the disappearance of substrate spots. Likewise, it would also allow for the preliminary detection of potential BHET byproducts during fungal incubation, prior to quantitative analyses performed by HPLC.
To obtain quantitative insights into BHET hydrolysis by S. commune BNT39, culture supernatants were analyzed by HPLC. Representative chromatograms are shown in Figure 2a. The standards mixture (BHET, MHET, TPA, and vanillic acid) was used to confirm retention times. These compounds were selected as reference standards because BHET and MHET are the principal intermediates of PET hydrolysis, while TPA represented the ultimate monomeric product of complete PET depolymerization, and its detection is therefore critical to assess degradation efficiency. Vanillic acid was additionally included as an aromatic benchmark, since recent studies have shown that microbial conversion of PET-derived terephthalate can yield value-added aromatics such as vanillic acid and related derivatives [9,15,25]. The inclusion of these standards allowed us not only to confirm retention times but also to anticipate the potential appearance of both canonical intermediates and secondary aromatic metabolites in fungal cultures. In the abiotic control (autoclaved BHET medium without fungal inoculum), in addition to the BHET peak, another signal was detected that did not match the retention time of any of the standards. Based on its spectral profile (UV absorbance 200–400 nm identical to BHET, Figure S1) and comparison with the literature, this peak was attributed to the BHET dimer [26,27]. Previous studies demonstrated that BHET exists both as a monomer and dimer, even the BHET commercial standard [27], and that these species can be resolved by HPLC, with different retention times and confirmed by complementary DSC and NMR analyses [22]. In aqueous UHPLC systems, the BHET dimer was often poorly soluble and thus less detectable, but its presence has been confirmed through thermal characterization (Tm ~164–170 °C) [22]. Our observation that autoclaving BHET-containing medium results in partial dimerization is consistent with previous reports describing abiotic transformations of BHET under heating or processing conditions [28]. Moreover, in PET biodegradation systems, dimers and other oligomers arise as secondary products as the reaction progresses, highlighting that abiotic processing can alter BHET speciation, an important consideration when interpreting controls [22]. UV detection of terephthalate esters at ~240–254 nm and C18 separations is standard in this field, aligning with our method [27,29,30].

Figure 2.
HPLC analysis of BHET degradation by Schizophyllum commune BNT39 grown on a liquid culture: (a) Stacked chromatograms of commercial standards (BHET, MHET, TPA, and vanillic acid) in red; abiotic control in blue, showing BHET and an additional peak attributed to BHET dimer; and fungal culture (30 d) in dark gray, showing complete BHET depletion, dimer accumulation, and TPA release. (b) Time courses (mean ± SE, n = 3) of BHET, BHET dimer, and TPA concentration. A.U.: arbitrary units.
The kinetic profile of BHET degradation by S. commune BNT39 (Figure 2b) could be clearly divided into three stages. During the initial phase (0–7 days), a sharp decrease in BHET concentration was observed, from 0.9520 ± 0.0866 mg/mL at day 0 to 0.0380 ± 0.0020 mg/mL at day 7, corresponding to a 96.0% reduction. In parallel, the BHET dimer increased from 0.5157 ± 0.0357 mg/mL to 0.8590 ± 0.0190 mg/mL (increased by 66%), while TPA concentrations increased consistently from 0.0165 ± 0.0025 mg/mL to 0.4095 ± 0.0435 mg/mL. These results indicated an active hydrolytic process in which BHET was rapidly consumed, leading to the accumulation of its dimer and the release of TPA. After the initial phase, a second stage took place (7–15 days). Once BHET was nearly exhausted, ≤0.0115 ± 0.0004 mg/mL at day 15 (98.8% reduction compared with the starting concentration), the system entered a plateau. In this interval, the BHET dimer remained essentially unchanged (0.8590 to 0.8143 mg/mL), and TPA concentrations stabilized (~0.41 mg/mL), suggesting that hydrolytic activity slowed in the absence of free BHET and that the dimer was not immediately accessible to further enzymatic conversion. In the third and final phase (15–30 days), a new dynamic emerged. The BHET dimer decreased markedly from 0.8143 ± 0.0283 mg/mL at day 15 to 0.5313 ± 0.0341 mg/mL at day 30 (−35%), while TPA nearly doubled, from 0.4160 ± 0.0340 to 0.7997 ± 0.0480 mg/mL (+92%). BHET remained almost completely depleted (0.0077 ± 0.0007 mg/mL). This pattern strongly suggests that, after the exhaustion of monomeric BHET, S. commune BNT39 was able to progressively hydrolyze the accumulated BHET dimer, ultimately driving further release of TPA. Taken together, this three-phase profile demonstrated that S. commune BNT39 not only rapidly consumed BHET but also, over extended incubation, was capable of utilizing BHET-derived dimers as substrates, leading to sustained TPA production.
These results confirmed that S. commune BNT39 was capable of efficiently hydrolyzing BHET and producing TPA as the main soluble end-product. The observed depletion of BHET and concomitant release of TPA by this strain is consistent with previous studies that highlight BHET as a central intermediate whose efficient bioconversion is essential for sustainable PET degradation strategies [9].
Three points merit further discussion. First, the accumulation of the BHET dimer was noteworthy: as previously reported, the dimer is less soluble than the monomer and tends to persist in culture, potentially limiting its bioavailability for enzymatic attack [28]. Second, some microbial enzymes have been described as having lower affinity for BHET dimer compared with other oligomers [28], which could explain the plateau observed in our assays (Figure 2b). Third, the three-phase degradation profile observed in S. commune BNT39 suggested a dynamic enzymatic system that may involve the sequential action of enzymes with different substrate preferences. The rapid depletion of monomeric BHET during the first phase indicated the activity of a BHETase-like enzyme, whereas the subsequent delay and later decline of the dimer fraction could reflect the activity of a secondary hydrolase acting on higher oligomers. This temporal succession was consistent with reports showing that fungal and bacterial polyester hydrolases can display distinct affinities toward BHET monomers and dimers [9,13]. A schematic representation of the proposed degradation pathway is shown in Figure 3, summarizing the sequential transformation of BHET into TPA and BHET dimer, and finally into TPA as the main product. This model highlights the potential cooperation between BHETase- and dimer–hydrolase-like activities within the extracellular enzyme pool of S. commune BNT39. Altogether, these results are consistent with the literature and highlight both the hydrolytic potential of S. commune BNT39 and the chemical complexity of BHET transformation pathways.

Figure 3.
Proposed enzymatic pathway for the biotransformation of BHET by Schizophyllum commune BNT39. The process occurs in two sequential phases: (1) a BHETase-like enzyme catalyzes the hydrolysis BHET; (2) a dimer-hydrolase-like enzyme further cleaves the intermediate into terephthalic acid (TPA) and ethylene glycol (EG). This scheme reflects the three-phase degradation profile observed experimentally, supporting the potential involvement of distinct enzymes with complementary substrate specificities.
3.2. Biodegradation of PET by Schizophyllum commune BNT39
As BHET hydrolysis served as an exploratory screen of polyester-degrading potential, we subsequently examined the fungus cultivated with micronized PET (<400 µm). At 15 and 30 days, only TPA was detected by HPLC, whereas neither MHET nor BHET peaks were observed, within the method’s detection limits. Quantitatively, TPA increased from 9.5 ± 0.5 mg/L (day 15) to 12.0 ± 1.33 mg/L (day 30), which represents a ~26% rise over the last two weeks of incubation (Figure 4). This increase, along with the absence of BHET and MHET, indicated net PET hydrolysis and suggested a rapid downstream conversion of soluble intermediates under the established conditions. Interestingly, no TPA was found at day 0 nor in the abiotic control over the 30-day incubation time.

Figure 4.
Biodegradation of PET by Schizophyllum commune BNT39. Terephthalic acid (TPA) release was quantified in culture supernatants after 15 and 30 days of incubation with micronized commercial PET (<400 μm). Data represent mean ± SE of triplicate experiments. Different letters indicate significant differences among time points (p < 0.05, Tukey post-test). No signals corresponding to BHET or MHET were detected under the established HPLC conditions.
From a recycling perspective, it is desirable to minimize the accumulation of MHET and BHET while maximizing the release of the monomers TPA and EG. Monomer recovery is the key step that enables true closed-loop routes back to PET or, alternatively, value-added upcycling. Indeed, several benchmark enzymatic systems reported exclusive soluble products as TPA and EG when PET is hydrolyzed efficiently, such as HiC and LCC, both genetically improved PETases/cutinases, under optimized conditions [31]. At the process scale, the same principles apply: sequential cutinase workflows can deliver TPA at very high purity (≈98%), showing why complete depolymerization is preferred over partial conversion that leaves MHET/BHET in solution [32]. Mechanistically, single PETase reactions often accumulate MHET, whereas coupling PETase with an MHET/BHET-active esterase (e.g., TfCa/cutinase) drives conversion to TPA as the sole product [28,33]. Because BHET and MHET can also inhibit polyester hydrolases, avoiding their accumulation further supports sustained reaction rates [33].
Our TPA-only profile aligned with this benchmark. The titers obtained here (9.5–12.0 mg/L at 30 °C, corresponding to 3.17–4 mg TPA/g PET) are modest but consistent with low-temperature fungal/cutinase systems. For instance, Fusarium cutinases released ~9–16 mg/L TPA from PET yarn after 168 h at 30 °C [34,35]. Comparable studies also use TPA as the mean readout, even when MHET/BHET remain detectable, while engineered Yarrowia lipolytica strains showed exclusively TPA under specific culture conditions [35].
Overall, the results indicated that S. commune BNT39 secretes enzymes capable of rapid and near-complete hydrolysis of PET intermediates to TPA under mild conditions. While TPA release was quantitatively assessed, additional evidence of polymer degradation, such as PET weight loss or morphological changes observed by SEM or FTIR, was not evaluated under the present conditions. These analyses will be pursued in future experiments to strengthen the assessment of the biodegradation performance of S. commune BNT39. Furthermore, although EG was not assayed here (UV-based HPLC at 250 nm does not detect it), the selective detection of TPA—and not MHET/BHET—supports the view that this strain promoted deep depolymerization, an advantageous trait for monomer recovery and circular PET valorization [31,32].
The relatively low TPA yields observed in this study may result from several limiting factors inherent to fungal PET degradation systems. First, enzyme stability likely declined over the 30-day incubation, reducing catalytic efficiency toward the end of the experiment. Additionally, the heterogeneous nature of PET restricts enzyme diffusion and substrate accessibility, particularly due to the high crystallinity of the polymer surface. The assays were conducted under mild temperature conditions (30 °C), which are far below the glass transition temperature of PET (~70 °C), where polymer chains become more flexible and more susceptible to enzymatic attack. Moreover, the extracellular hydrolases secreted by S. commune may possess lower intrinsic affinity for PET compared with bacterial PETases or engineered cutinases. Similar limitations related to enzyme adsorption and stability have been reported for fungal systems using Penicillium and Aspergillus species under comparable conditions [13,36]. These aspects highlight the need for future optimization of enzyme production, stabilization, and reaction parameters to enhance PET depolymerization efficiency.
Furthermore, recent studies have demonstrated that combining multiple microbial or enzymatic systems can significantly enhance PET depolymerization efficiency. For instance, Ideonella sakaiensis PETase and MHETase act cooperatively to achieve complete PET hydrolysis into TPA and EG, highlighting the catalytic synergy between enzymes targeting distinct intermediates [37,38]. Similarly, fungal–bacterial consortia, such as Aspergillus niger and Trichoderma harzianum, have been shown to promote complementary enzymatic actions—lipases, cutinases, and oxidoreductases—resulting in increased PET surface erosion and TPA release under mild conditions [37]. Engineered co-cultures and enzyme cocktails integrating cutinases, PETases, and MHETases are also being developed to improve reaction rates and substrate accessibility in scalable bioprocesses [37,39]. These approaches illustrate the growing trend toward bioprocess integration and multi-enzyme cooperation as strategies to overcome the kinetic and diffusional limitations typically observed in single-enzyme systems. In this context, the enzymatic activity of S. commune BNT39 could potentially complement bacterial PETases or be incorporated into multi-enzyme consortia to enhance the biodegradation of PET and its intermediates at moderate temperatures.
3.3. Extraction and Confirmation of Cutin
Cutin is a highly hydrophobic network polymer that forms the outer protective layer of terrestrial plants; it is composed predominantly of C16-C18 ω-hydroxy/epoxy fatty acids cross-linked through ester bonds, with glycerol as a minor co-monomer [10,12]. Notably, cutinase (EC 3.1.1.74) was described as an inducible enzyme in phytopathogenic fungi upon contact with plant cutin, underscoring the rationale for employing a natural cutin source in our system [10]. Because cutin is the native polyester of the plant cuticle and a recognized physiological inducer of fungal cutinase expression, we prepared laboratory-grade cutin from apple peel to support the downstream stimulation assays. Moreover, apple cuticle has been explicitly used as an induction source for fungal cutinase transcription and activity, including the upregulation of Moniliophthora roreri cutinase genes, which supports our choice of apple peel as feedstock [3].
Apple peels were processed as described in Section 2.4 to yield an insoluble, waxy polymeric fraction. The identity of the recovered material as cutin was confirmed by FTIR spectroscopy. The spectrum (Figure 5) exhibited the expected features for plant cutin: a strong ester C=O band near ~1730 cm−1, prominent C-O stretching bands within ~1100–1300 cm−1, aliphatic C-H stretches at ~2918 and ~2848 cm−1, and a broad O-H band in the 3200–3500 cm−1 region. These signatures are consistent with published FTIR assignments for isolated fruit-cuticle cutin [3,40].

Figure 5.
FTIR spectrum of lyophilized apple peel-derived cutin. The spectrum exhibited characteristic cutin features: a broad O-H stretch (blue) at ~3200–3500 cm−1, strong aliphatic -CH2- stretches (green) at ~2918 and ~2848 cm−1, an ester carbonyl ν(C=O) band (purple) near ~1730 cm−1, and C-O-C stretching vibrations (orange) in the ~1100–1300 cm−1 region. These assignments confirmed the polyester nature of the extracted material and were consistent with reported vibrational profiles of plant cutin [3,40].
Establishing a reliable in-house source of cutin was necessary because commercial material is intermittently unavailable and because a plant-derived inducer is directly relevant to fungal physiology. In addition, cutinases produced by fungi are known to act not only on their natural substrate but also on synthetic polyesters (e.g., PCL and PET) [12,34], providing a mechanistic bridge to the precedent PET/BHET biodegradation results reported here.
3.4. Stimulation of Cutinase Activity in Schizophyllum commune BNT39
To probe whether small molecules and polymeric substrates enhance extracellular cutinase production, S. commune BNT39 was cultivated in YP 50% supplemented with one of four compounds: micronized PET, PCL, BHET, or apple cutin. As mentioned above, cutin was included because plant cuticles are the native substrate for fungal cutinases [3]. In parallel, PCL was tested as a synthetic aliphatic polyester and structural analogue of cutin, commonly employed to probe and stimulate cutinase-like activities in fungi [10,41]. PET was included to assess whether the recalcitrant target polymer itself could act as a potential inducer [10,12]. Finally, BHET was evaluated as a potential exploratory inducer, given previous reports that it can stimulate the production of ester-hydrolases (lipases/esterases) in certain fungi [24].
Across all conditions, secreted p-nitrophenyl butyrate-hydrolyzing activity (expressed as U/L) exhibited an early peak followed by a progressive decline (Figure 6). Cutin was the most effective compound that enhanced enzyme activity, reaching 547.6 ± 32.2 U/L at day 4 (~4.3-fold over the control, 127.3 ± 4.2 U/L), followed by 439.6 ± 17.5 U/L at day 6, 313.7 ± 12.3 U/L at day 8, and 23.3 ± 1.2 U/L at day 15. BHET showed an intermediate profile, peaking at 307.9 ± 10.6 U/L on day 6 (~1.55× the control at that time), with 162.4 ± 4.2 U/L (day 4), 214.6 ± 11.6 U/L (day 8), and 81.8 ± 2.6 U/L (day 15). PCL gave moderate stimulation: 240.2 ± 12.6, 247.2 ± 17.4, 146.2 ± 6.5, and 38.8 ± 1.5 U/L at days 4, 6, 8, and 15, respectively; while the PET condition produced marginal activity (131.8 to 95.0 U/L). Collectively, these patterns indicate a 4–6 day window as optimal for harvesting maximal extracellular activity, with the order of effectiveness being cutin >> BHET ≥ PCL > PET ≈ control.

Figure 6.
Induction of extracellular cutinase activity in Schizophyllum commune BNT39 by different substrates. Cultures were grown in YP 50% medium supplemented with apple cutin, BHET, PCL, or micronized PET, and compared with a control (YP 50% only). Cutinase activity was quantified using p-nitrophenyl butyrate (PNPB) hydrolysis. Data represent mean ± SE of three independent experiments, each measured in technical triplicate. Different letters indicate significant differences among substrates within each incubation time (p < 0.05, Tukey post-test).
Given the ecological role of cutin as a native polymer that strongly stimulates fungal cutinases, our results were consistent with this function. This effect has been documented at the transcriptional level in the fungus Moniliophthora roreri, where apple and cacao cuticles served as defined induction sources [3]. In turn, the moderate response to PCL is consistent with its common use as a cutin-mimicking substrate in plate assays, where clearing halos reveal the action of secreted polyesterases [41]. The stronger effect of BHET over PET is plausible given its higher solubility and capacity to trigger ester-hydrolase production in fungi, whereas PET’s low bioavailability usually limits early induction unless engineered cutinases and elevated temperatures are applied [10,24].
Notably, the temporal induction profile matched our depolymerization assays: peak enzyme activity (days 4–6) coincided with the sharp decline in BHET and the initial rise in TPA in liquid cultures (Figure 2b), indicating that secreted cutinase/esterase activities contribute to BHET hydrolysis in S. commune BNT39. Conversely, PET produced only weak activity, matching the modest TPA titers observed (Figure 4) and consistent with reports that efficient PET conversion generally requires robust or engineered cutinase systems together with optimized culture conditions, particularly temperature [10].
While the enzymatic activity in this study was evaluated using pNP-butyrate as a general esterase substrate, the stimulation pattern observed upon cutin supplementation is consistent with the behavior reported for cutinases. Cutinases were known to be secreted in response to cutin or cutin-derived monomers and to function efficiently in aqueous environments, where classical lipases—usually requiring interfacial activation on water–insoluble long-chain esters—show little or no activity. In our study, pNPB hydrolysis increased in cutin-stimulated cultures. At the same time, control conditions showed minimal activity, suggesting the expression of enzymes responsive to cuticular substrates rather than broad-spectrum lipases or nonspecific esterases. This response, combined with the origin of our strain, is in line with the functional properties described for fungal cutinases. Cutinases are believed to play an important role in the penetration of plant surfaces. In fact, the strains producing the highest cutinase activities were found among plant pathogens that also showed the highest activity towards pNP-butyrate [42]. Together, these features support the notion that the stimulated activity represents a cutinase-like system for the hydrolysis of plant polyester rather than general lipid degradation. Future studies will aim to further clarify this aspect, such as by assessing enzyme activity in cutin-containing media using longer-chain fatty acid esters as substrates, thereby providing a more precise distinction between cutinase and lipase-like activities. Moreover, PETases share structural homology with cutinases but possess a wider and more open substrate-binding cleft, enabling accommodation of bulky PET chains [43]. In this context, subsequent experiments will also explore whether the enzyme characterized here exhibits PETase-like features. In this work, enzymatic activity was expressed in units per liter (U/L) of culture supernatant, a suitable measure to compare temporal trends in enzyme secretion under the tested conditions. Future studies will complement this approach by determining specific activity (U/mg protein) to enable a more standardized comparison across fungal systems and culture media.
Altogether, these results show that apple cutin was the most potent biological compound that enhanced extracellular cutinase activity in S. commune BNT39. This finding suggests a practical route for process intensification: employing natural cutin (or cutin-mimicking inducers) to enhance enzyme titers prior to crude enzyme application on PET depolymerization, a strategy consistent with the established role of cutinases in polyester breakdown [3,12].
4. Conclusions
This study demonstrates that Schizophyllum commune BNT39 is capable of hydrolyzing BHET and PET, releasing TPA as the main soluble end-product. The fungus showed a distinct three-phase degradation profile, including the progressive utilization of BHET dimers, and PET assays confirmed selective TPA release without detectable intermediates. Specific experiments further revealed that apple-derived cutin strongly stimulated extracellular cutinase activity, supporting its potential to enhance enzymatic depolymerization of PET. Although PET degradation remained modest, these results highlight the enzymatic versatility of S. commune BNT39 and its relevance as a fungal model for polyester hydrolysis. Future work should identify the specific enzymes involved, characterize their biochemical properties, and optimize culture strategies to increase monomer yields and enhance PET depolymerization efficiency. The enzymatic system described herein also opens promising avenues for scale-up and industrial application. Efforts should focus on optimizing reaction parameters—such as substrate pretreatment near the polymer’s glass transition temperature (Tg) and bioreactor configuration—to improve enzyme titers and process performance. From an applied perspective, exploring enzyme upscaling and immobilization will be key to enhancing catalytic stability, reusability, and operational continuity. Implementing immobilized S. commune enzymes in bioreactor systems could strengthen PET–enzyme interactions, enable continuous operation, and contribute to the development of scalable biocatalytic processes for sustainable PET recycling.
Supplementary Materials
The following supporting information can be downloaded at: https://www.mdpi.com/article/10.3390/pr13113663/s1, Figure S1: UV-Vis absorbance spectra of BHET (red) and BHET dimer (blue) recorded between 200–400 nm.
Author Contributions
Conceptualization, F.G.M., V.C.M., C.M.R. and A.Á.; formal analysis, F.G.M., V.C.M. and V.G.A.; investigation, F.G.M., V.C.M. and C.E.P.; data curation, F.G.M. and C.E.P.; writing—original draft preparation, F.G.M., V.C.M., C.E.P. and F.Z.; writing—review and editing, C.M.R. and A.Á.; visualization, F.G.M.; supervision, C.M.R. and A.Á.; project administration, C.M.R. and A.Á.; funding acquisition, C.M.R. and A.Á. All authors have read and agreed to the published version of the manuscript.
Funding
This research was funded by the National Scientific and Technical Research Council (CONICET, Argentina).
Data Availability Statement
The DNA sequence generated in this study (LSU rDNA gene, amplified using ITS1 and NL4 primers) has been deposited in the GenBank database under the accession number PX026298, submitted on 30 July 2025.
Conflicts of Interest
The authors declare no conflicts of interest.
Abbreviations
The following abbreviations are used in this manuscript:
| BHET | bis (2-hydroxyethyl) terephthalate |
| MHET | mono (2-hydroxyethyl) terephthalate |
| TPA | terephthalic acid |
| TLC | thin-layer chromatography |
| EG | ethylene glycol |
| PCL | polycaprolactone |
References
- Verschoor, J.-A.; Croese, M.R.; Lakemeier, S.E.; Mugge, A.; Burgers, C.M.; Innocenti, P.; Willemse, J.; Crooijmans, M.E.; Van Wezel, G.P.; Ram, A.F. Polyester degradation by soil bacteria: Identification of conserved BHETase enzymes in Streptomyces. Commun. Biol. 2024, 7, 725. [Google Scholar] [CrossRef]
- Tegariyanto, M.; Titah, H.; Pratikno, H. Biodegradation of polyethylene terephthalate (PET) plastics using a combination of Aspergillus niger and Trichoderma harzianum. In IOP Conference Series: Earth and Environmental Science; IOP Publishing: Bristol, UK, 2024. [Google Scholar] [CrossRef]
- Vázquez-Alcántara, L.; Oliart-Ros, R.M.; García-Bórquez, A.; Peña-Montes, C. Expression of a cutinase of Moniliophthora roreri with polyester and PET-plastic residues degradation activity. Microbiol. Spectr. 2021, 9, e00976-21. [Google Scholar] [CrossRef] [PubMed]
- Huang, Q.-S.; Chen, S.-Q.; Zhao, X.-M.; Song, L.-J.; Deng, Y.-M.; Xu, K.-W.; Yan, Z.-F.; Wu, J. Enhanced degradation of polyethylene terephthalate (PET) microplastics by an engineered Stenotrophomonas pavanii in the presence of biofilm. Sci. Total Environ. 2024, 955, 177129. [Google Scholar] [CrossRef] [PubMed]
- Temporiti, M.E.E.; Nicola, L.; Nielsen, E.; Tosi, S. Fungal enzymes involved in plastics biodegradation. Microorganisms 2022, 10, 1180. [Google Scholar] [CrossRef]
- Kawai, F.; Iizuka, R.; Kawabata, T. Engineered polyethylene terephthalate hydrolases: Perspectives and limits. Appl. Microbiol. Biotechnol. 2024, 108, 404. [Google Scholar] [CrossRef]
- Tournier, V.; Duquesne, S.; Guillamot, F.; Cramail, H.; Taton, D.; Marty, A.; André, I. Enzymes’ power for plastics degradation. Chem. Rev. 2023, 123, 5612–5701. [Google Scholar] [CrossRef]
- Kaur, K.; Sharma, S.; Shree, N.; Mehrotra, R. A Comprehensive Review on the Diverse Arsenal of PET-Degrading Organisms. Int. J. Innov. Multidiscip. Res. 2024, 3, 22–32. [Google Scholar]
- Ion, S.; Voicea, S.; Sora, C.; Gheorghita, G.; Tudorache, M.; Parvulescu, V.I. Sequential biocatalytic decomposition of BHET as valuable intermediator of PET recycling strategy. Catal. Today 2021, 366, 177–184. [Google Scholar] [CrossRef]
- Sahu, S.; Kaur, A.; Khatri, M.; Singh, G.; Arya, S.K. A review on cutinases enzyme in degradation of microplastics. J. Environ. Manag. 2023, 347, 119193. [Google Scholar] [CrossRef]
- Ahmaditabatabaei, S.; Kyazze, G.; Iqbal, H.M.; Keshavarz, T. Fungal enzymes as catalytic tools for polyethylene terephthalate (PET) degradation. J. Fungi 2021, 7, 931. [Google Scholar] [CrossRef]
- Won, S.-J.; Yim, J.H.; Kim, H.-K. Functional production, characterization, and immobilization of a cold-adapted cutinase from Antarctic Rhodococcus sp. Protein Expr. Purif. 2022, 195, 106077. [Google Scholar] [CrossRef] [PubMed]
- Moyses, D.N.; Teixeira, D.A.; Waldow, V.A.; Freire, D.M.; Castro, A.M. Fungal and enzymatic bio-depolymerization of waste post-consumer poly (ethylene terephthalate)(PET) bottles using Penicillium species. 3 Biotech 2021, 11, 435. [Google Scholar] [CrossRef] [PubMed]
- Vanaraj, R.; Suresh Kumar, S.M.; Kim, S.C.; Santhamoorthy, M. A review on sustainable upcycling of plastic waste through depolymerization into high-value monomer. Processes 2025, 13, 2431. [Google Scholar] [CrossRef]
- Jiang, C.; Zhai, K.; Wright, R.C.; Chen, J. Engineered Yeasts Displaying PETase and MHETase as Whole-Cell Biocatalysts for the Degradation of Polyethylene Terephthalate (PET). ACS Synth. Biol. 2025, 14, 2810–2820. [Google Scholar] [CrossRef]
- Fernandez, R.D.; Bulacio, N.; Álvarez, A.; Pajot, H.; Aragón, R. Fungal decomposers of leaf litter from an invaded and native mountain forest of NW Argentina. Antonie Leeuwenhoek 2017, 110, 1207–1218. [Google Scholar] [CrossRef]
- Suárez, G.M.; Dominguez, F.G.; Pajot, H.; Flores, J.R.; Catania, M.D.V. Octospora tucumanensis (Pezizales), a new bryophilous ascomycete on Dimerodontium balansae (Bryophyta) from Argentina. Mycol. Prog. 2023, 22, 54. [Google Scholar] [CrossRef]
- Sánchez Novoa, J.G.; Domínguez, F.G.; Pajot, H.; De Cabo, L.I.; Navarro Llorens, J.M.; Marconi, P.L. Isolation and assessment of highly sucrose-tolerant yeast strains for honey processing factory’s effluent treatment. AMB Express 2024, 14, 125. [Google Scholar] [CrossRef]
- Melinas Ciller, A.C.; Jiménez Migallón, A.; Garrigós Selva, M.d.C. Method for Obtaining Cutin from Plant Waste and Cutin Obtained. WO2023/198943 A1, 19 October 2023. [Google Scholar]
- Ping, L.-F.; Chen, X.-Y.; Yuan, X.-L.; Zhang, M.; Chai, Y.-J.; Shan, S.-D. Application and comparison in biosynthesis and biodegradation by Fusarium solani and Aspergillus fumigatus cutinases. Int. J. Biol. Macromol. 2017, 104, 1238–1245. [Google Scholar] [CrossRef]
- Kleijburg, F.E.; Wösten, H.A. The versatility of Schizophyllum commune in nature and application. Fungal Biol. Rev. 2025, 53, 100431. [Google Scholar] [CrossRef]
- Imran, M.; Kim, B.-K.; Han, M.; Cho, B.G.; Kim, D.H. Sub-and supercritical glycolysis of polyethylene terephthalate (PET) into the monomer bis (2-hydroxyethyl) terephthalate (BHET). Polym. Degrad. Stab. 2010, 95, 1686–1693. [Google Scholar] [CrossRef]
- Lee, S.H.; Kim, M.; Seo, H.; Hong, H.; Park, J.; Ki, D.; Kim, K.-J. Characterization and engineering of a fungal poly (ethylene terephthalate) hydrolyzing enzyme from Aspergillus fumigatiaffinis. ACS Catal. 2024, 14, 4108–4116. [Google Scholar] [CrossRef]
- Liu, X.-H.; Jin, J.-L.; Sun, H.-T.; Li, S.; Zhang, F.-F.; Yu, X.-H.; Cao, Q.-Z.; Song, Y.-X.; Li, N.; Lu, Z.-H. Perspectives on the microorganisms with the potentials of PET-degradation. Front. Microbiol. 2025, 16, 1541913. [Google Scholar] [CrossRef] [PubMed]
- Soong, Y.H.V.; Abid, U.; Chang, A.C.; Ayafor, C.; Patel, A.; Qin, J.; Xu, J.; Lawton, C.; Wong, H.W.; Sobkowicz, M.J. Enzyme selection, optimization, and production toward biodegradation of post-consumer poly (ethylene terephthalate) at scale. Biotechnol. J. 2023, 18, 2300119. [Google Scholar] [CrossRef]
- Zahova, S.; Tsacheva, I.; Troev, K.; Mitova, V. Conventional and MW assisted PET glycolysis promoted by titanium based catalyst. Polym. Degrad. Stab. 2023, 212, 110353. [Google Scholar] [CrossRef]
- Kim, E.H.; Park, I.; Kim, S.; Kim, J.F.; Choi, Y.H.; Lee, H. Chemical recycling of polyethylene terephthalate using a micro-sized MgO-incorporated SiO2 catalyst to produce highly pure bis (2-hydroxyethyl) terephthalate in high yield. Chem. Eng. J. 2024, 499, 155865. [Google Scholar] [CrossRef]
- Menzel, T.; Weigert, S.; Gagsteiger, A.; Eich, Y.; Sittl, S.; Papastavrou, G.; Ruckdäschel, H.; Altstädt, V.; Höcker, B. Impact of enzymatic degradation on the material properties of poly (ethylene terephthalate). Polymers 2021, 13, 3885. [Google Scholar] [CrossRef]
- Puspitasari, N.; Tsai, S.-L.; Lee, C.-K. Class I hydrophobins pretreatment stimulates PETase for monomers recycling of waste PETs. Int. J. Biol. Macromol. 2021, 176, 157–164. [Google Scholar] [CrossRef]
- Yao, J.; Liu, Y.; Gu, Z.; Zhang, L.; Guo, Z. Deconstructing PET: Advances in enzyme engineering for sustainable plastic degradation. Chem. Eng. J. 2024, 497, 154183. [Google Scholar] [CrossRef]
- Hwang, D.-H.; Lee, M.-E.; Cho, B.-H.; Oh, J.W.; You, S.K.; Ko, Y.J.; Hyeon, J.E.; Han, S.O. Enhanced biodegradation of waste poly (ethylene terephthalate) using a reinforced plastic degrading enzyme complex. Sci. Total Environ. 2022, 842, 156890. [Google Scholar] [CrossRef]
- Chen, K.; Dong, X.; Sun, Y. Sequentially co-immobilized PET and MHET hydrolases via Spy chemistry in calcium phosphate nanocrystals present high-performance PET degradation. J. Hazard. Mater. 2022, 438, 129517. [Google Scholar] [CrossRef] [PubMed]
- von Haugwitz, G.; Han, X.; Pfaff, L.; Li, Q.; Wei, H.; Gao, J.; Methling, K.; Ao, Y.; Brack, Y.; Mican, J. Structural insights into (tere) phthalate-ester hydrolysis by a carboxylesterase and its role in promoting PET depolymerization. ACS Catal. 2022, 12, 15259–15270. [Google Scholar] [CrossRef] [PubMed]
- Kosiorowska, K.E.; Biniarz, P.; Dobrowolski, A.; Leluk, K.; Mirończuk, A.M. Metabolic engineering of Yarrowia lipolytica for poly (ethylene terephthalate) degradation. Sci. Total Environ. 2022, 831, 154841. [Google Scholar] [CrossRef]
- Kosiorowska, K.E.; Moreno, A.D.; Iglesias, R.; Leluk, K.; Mirończuk, A.M. Production of PETase by engineered Yarrowia lipolytica for efficient poly (ethylene terephthalate) biodegradation. Sci. Total Environ. 2022, 846, 157358. [Google Scholar] [CrossRef]
- Qi, X.; Yan, W.; Cao, Z.; Ding, M.; Yuan, Y. Current advances in the biodegradation and bioconversion of polyethylene terephthalate. Microorganisms 2021, 10, 39. [Google Scholar] [CrossRef]
- Yoshida, S.; Hiraga, K.; Taniguchi, I.; Oda, K. Ideonella sakaiensis, PETase, and MHETase: From identification of microbial PET degradation to enzyme characterization. In Methods in Enzymology; Elsevier: Amsterdam, The Netherlands, 2021; pp. 187–205. [Google Scholar] [CrossRef]
- Wang, C.; Long, R.; Lin, X.; Liu, W.; Zhu, L.; Jiang, L. Development and characterization of a bacterial enzyme cascade reaction system for efficient and stable PET degradation. J. Hazard. Mater. 2024, 472, 134480. [Google Scholar] [CrossRef]
- Shingwekar, D.; Laster, H.; Kemp, H.; Mellies, J.L. Two-step chemo-microbial degradation of post-consumer polyethylene terephthalate (PET) plastic enabled by a biomass-waste catalyst. Bioengineering 2023, 10, 1253. [Google Scholar] [CrossRef] [PubMed]
- Heredia-Guerrero, J.A.; Benítez, J.J.; Domínguez, E.; Bayer, I.S.; Cingolani, R.; Athanassiou, A.; Heredia, A. Infrared and Raman spectroscopic features of plant cuticles: A review. Front. Plant Sci. 2014, 5, 305. [Google Scholar] [CrossRef] [PubMed]
- Malafatti-Picca, L.; Bucioli, E.C.; De Barros Chaves, M.R.; De Castro, A.M.; Valoni, É.; De Oliveira, V.M.; Marsaioli, A.J.; Govone, J.S.; De Franceschi de Angelis, D.; Brienzo, M. Fungal screening for potential PET depolymerization. Polymers 2023, 15, 1581. [Google Scholar] [CrossRef]
- Halonen, P.; Reinikainen, T.; Nyyssölä, A.; Buchert, J. A high throughput profiling method for cutinolytic esterases. Enzym. Microb. Technol. 2009, 44, 394–399. [Google Scholar] [CrossRef]
- Han, X.; Liu, W.; Huang, J.-W.; Ma, J.; Zheng, Y.; Ko, T.-P.; Xu, L.; Cheng, Y.-S.; Chen, C.-C.; Guo, R.-T. Structural insight into catalytic mechanism of PET hydrolase. Nat. Commun. 2017, 8, 2106. [Google Scholar] [CrossRef]
Disclaimer/Publisher’s Note: The statements, opinions and data contained in all publications are solely those of the individual author(s) and contributor(s) and not of MDPI and/or the editor(s). MDPI and/or the editor(s) disclaim responsibility for any injury to people or property resulting from any ideas, methods, instructions or products referred to in the content. |
© 2025 by the authors. Licensee MDPI, Basel, Switzerland. This article is an open access article distributed under the terms and conditions of the Creative Commons Attribution (CC BY) license (https://creativecommons.org/licenses/by/4.0/).






